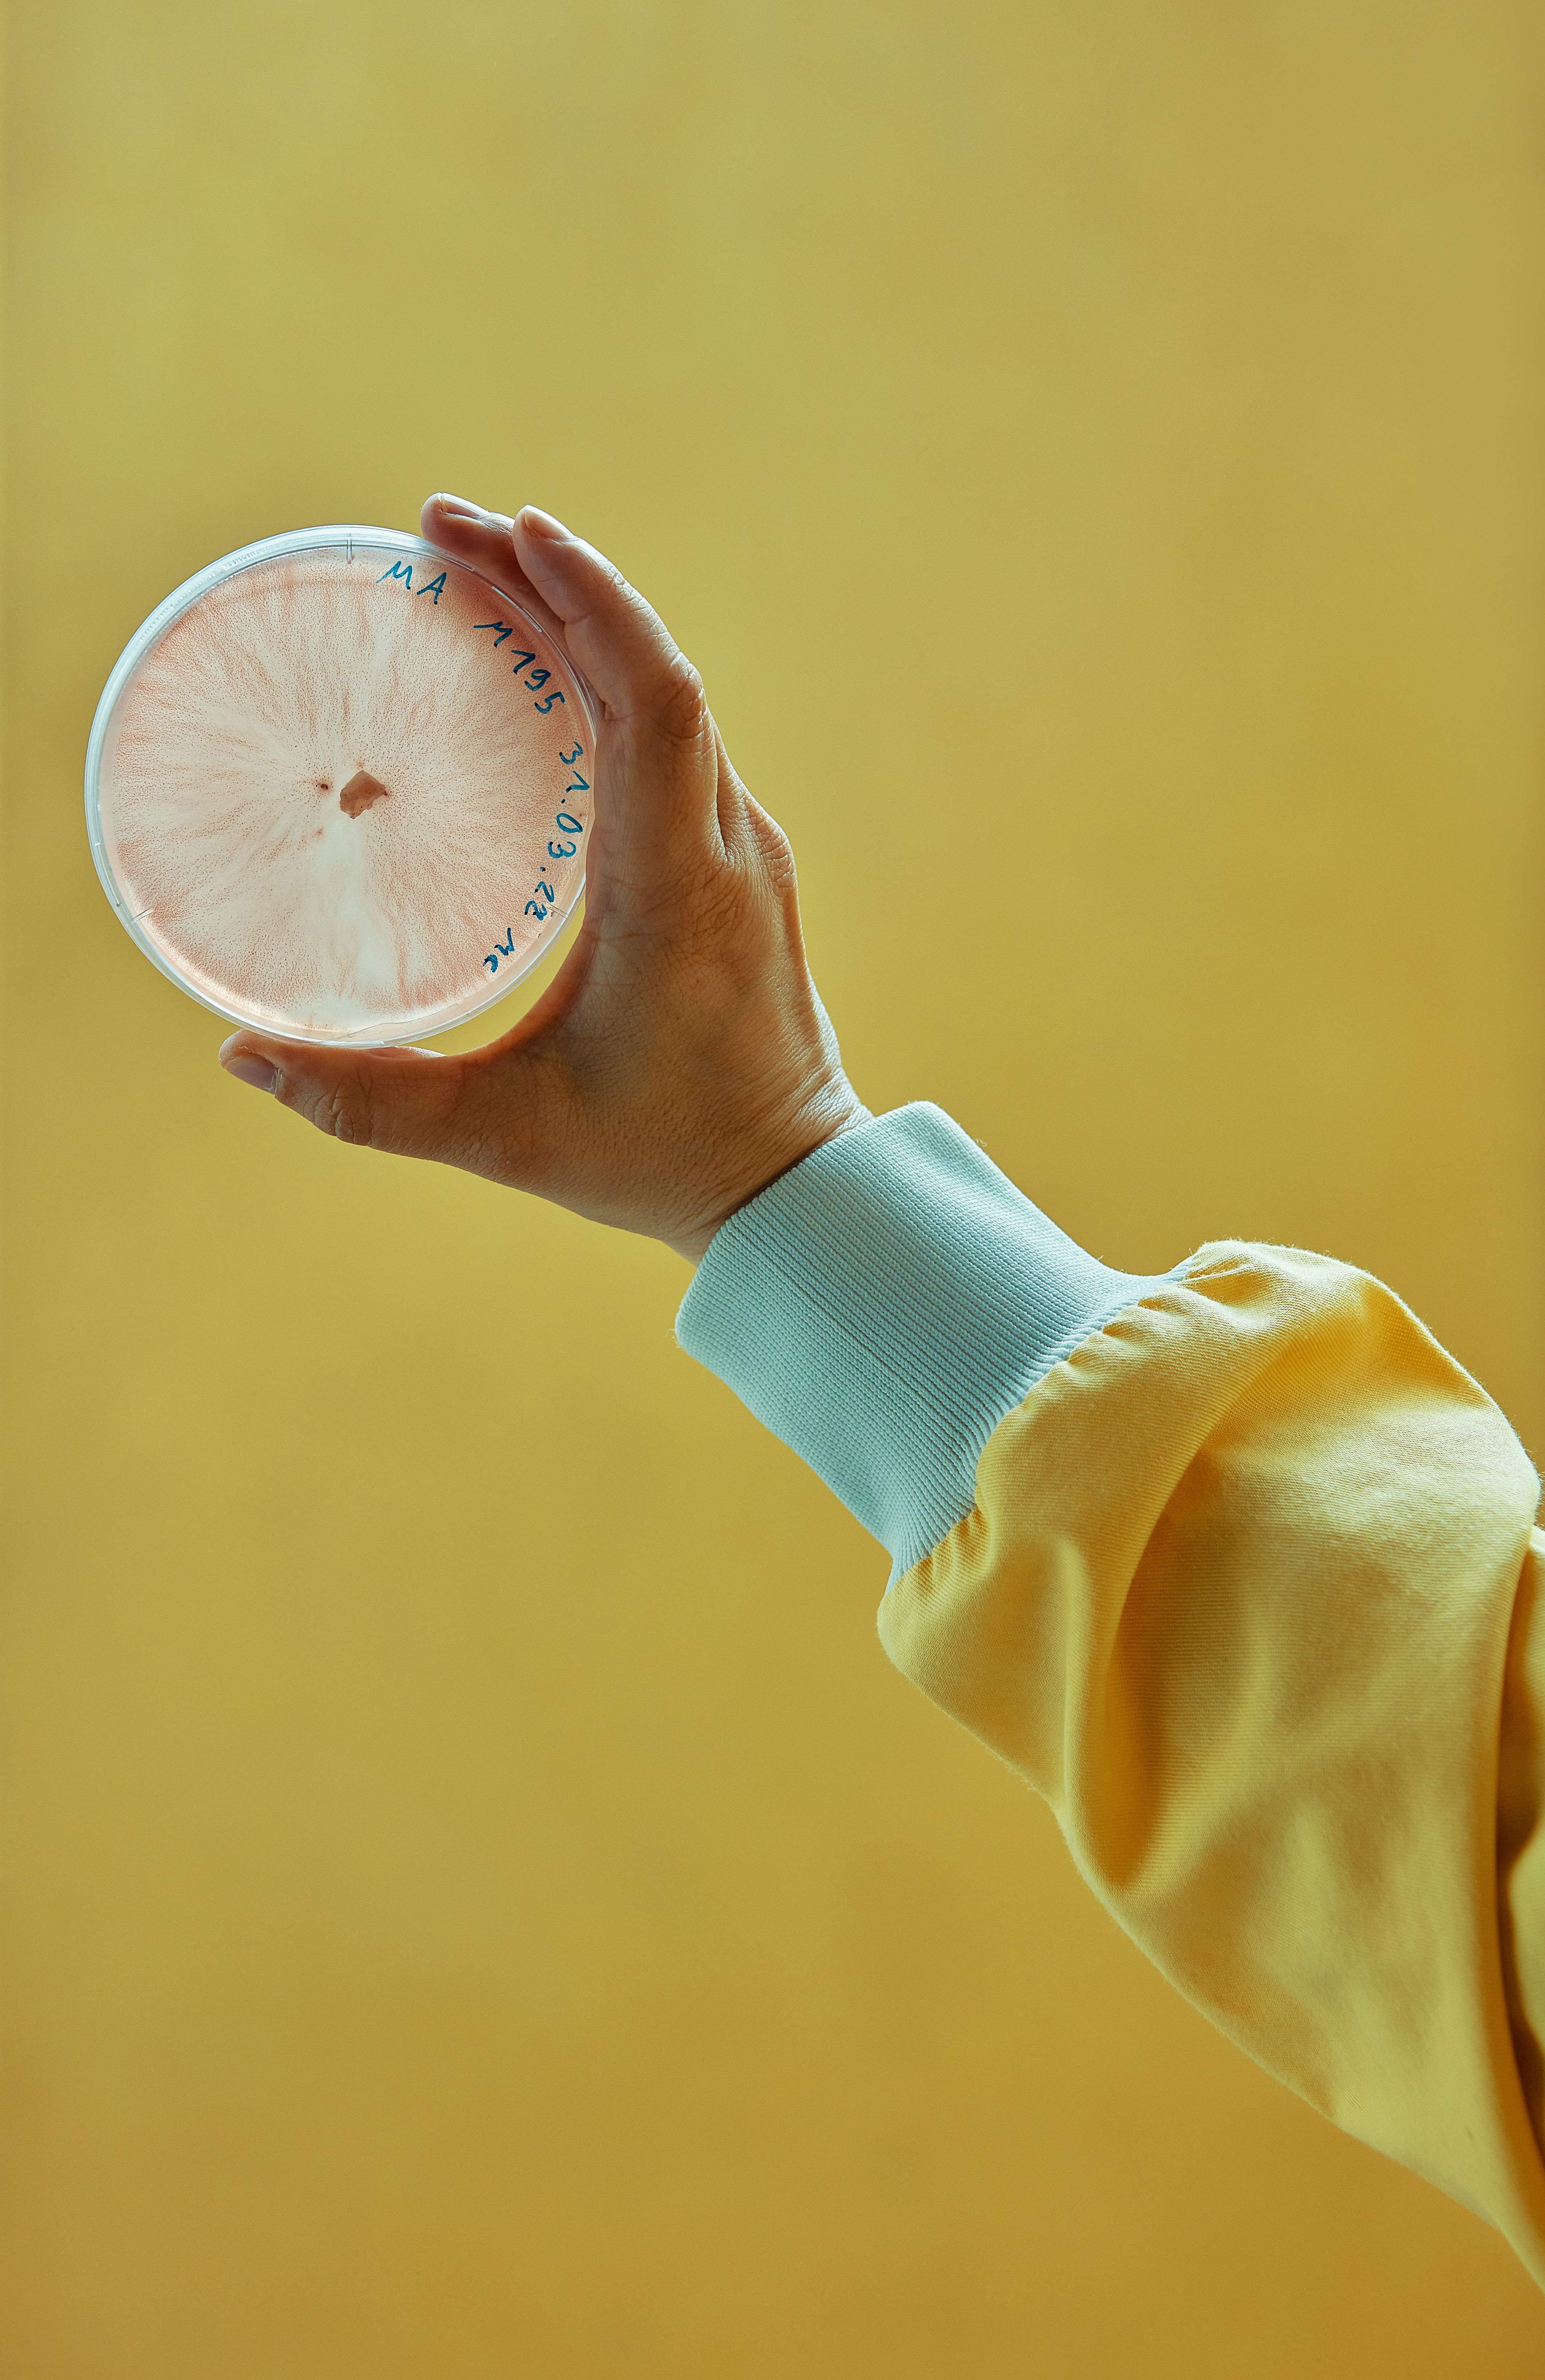
content-image

Inhalt
Inhalt Spieltrieb
Spieltrieb Regeneration
Regeneration Patienten als Partner
Patienten als PartnerPubliziert am 30/09/2022
Die meisten Menschen leiden mit zunehmendem Alter an kognitivem Abbau. Oft ist dieser ein Symptom von traumatischen Hirnverletzungen oder degenerativen Erkrankungen wie Alzheimer oder Parkinson. Diese Krankheiten sind unheilbar, doch kognitiv stimulierende Spiele können helfen, den geistigen Verfall zu verlangsamen. Anhand solcher Computergames könnten sich Ärzte, die ihre Patienten in der Regel nur ein- oder zweimal im Jahr sehen, von deren Rück- und Fortschritten ein kontinuierlicheres, unvoreingenommeneres Bild machen. Trotz dieser potenziellen Vorteile sind jedoch bisher keine klinisch validierten Spiele auf dem Markt. Grund dafür ist die Tatsache, dass die Entwicklung wirksamer Spiele und der Nachweis ihres Nutzens für diesen Bereich eine grosse Herausforderung darstellen – der sich Prabitha Urwyler im Rahmen eines FreeNovation-Projekts stellte.
Beim Start des Projekts 2018 leitete Urwyler die Erforschung des kognitiven Trainings am ARTORG Center for Biomedical Engineering Research, Gerontechnology and Rehabilitation der Universität Bern. In Zusammenarbeit mit der benachbarten Memory Clinic arbeitete sie in ihrem Projekt zunächst mit Fokusgruppen, um festzustellen, welche Arten von Spielen den Teilnehmenden am meisten Spass machen (Rätsel und Strategiespiele). Daraufhin entwickelte das Team von Urwyler zwei Spiele, um spezifische kognitive Fähigkeiten zu trainieren: ein Zuordnungsspiel für die visuelle Suche und ein Labyrinthspiel für die räumliche Orientierungsfähigkeit. Um sicherzustellen, dass sich die Spiele anpassen lassen und die Spielerinnen und Spieler ständig herausfordern, hat das Team auch KI-Algorithmen integriert. Um die Ergebnisse nicht zu verfälschen, stellte Urwyler sicher, dass die Spiele ohne Sprache funktionieren, so dass alle ungeachtet ihrer Sprachkenntnisse das Spiel problemlos verstehen und spielen können. Als die Spiele schliesslich in einem klinischen Umfeld getestet werden konnten, sah sich das Projekt mit den unvorhergesehenen Herausforderungen der COVID-19-Pandemie konfrontiert. Mit einigen weiteren Anpassungen, wie dem Versand von Tablet-Computern an die Patienten und telefonischen Anweisungen zu den Spielen, konnte Urwyler dennoch eine kleine Konzeptionsstudie durchführen. Die Ergebnisse waren so erfolgreich, dass nun die nächsten Schritte für das Projekt erörtert werden. Eine überarbeitete Machbarkeitsstudie und eine gross angelegte internationale klinische Studie sind geplant. Dabei sollen neue Interaktionsmöglichkeiten mit einer breiteren Produktpalette durch das Start-up-Unternehmen Neurometry mit dessen Forschungs- und Klinikpartnern getestet werden.
Blockchain
Die Blockchain-Technologie, die das Potenzial haben soll, digitale Systeme vollständig sicher zu machen, ist für viele Menschen noch ein Buch mit sieben Siegeln. Die Mitglieder eines funktionsübergreifenden Teams von Novartis sind aber davon überzeugt, dass mit der Blockchain-Technologie die pharmazeutische Industrie grundlegend verändert werden kann. Nicht nur die Verteilung von Medikamenten soll dadurch sicherer werden, sondern auch der Kontakt zu Patienten soll sich so direkter und persönlicher gestalten lassen.
Das war die Grundidee, als Marco Cuomo und Daniel Fritz 2018 ein europaweites Forschungsprojekt starteten, das nun, vier Jahre später, die ersten Früchte trägt und aus dem im kommenden Jahr ein grösserer, branchenweiter Verband entstehen könnte. «Als wir uns mit der Möglichkeit befassten, die Blockchain-Technologie zu nutzen, wurde uns schnell klar, dass wir dies nur mit starker interner Unterstützung und externen Partnern tun könnten – Blockchain ist ein Mannschaftssport», so Cuomo. «Daraufhin haben wir uns an Gwenaelle Nicolas gewandt, die uns dabei unterstützt hat, mit der Innovative Medicines Initiative der Europäischen Union ein Projekt auf die Beine zu stellen.»
Das Projekt, das unter dem Namen PharmaLedger firmiert, stiess früh auf reges Interesse in der Branche. Heute gehören ihm fast 30 Organisationen an, darunter 12 Pharmaunternehmen. Es handelt sich um ein Netzwerk von rund 200 Personen, die mit Hochdruck daran arbeiten, die Grundlagen für eine branchenweite Einführung dieser Technologie zu schaffen.
Mit der tatkräftigen Unterstützung von Novartis Technical Operations hat das Team den Weg für die Einführung elektronischer Produktinformationen geebnet, die eines Tages die heute üblichen Papierbeipackzettel ersetzen könnten. Dies würde Geld sparen und auch die Abfallmenge sowie den CO2-Ausstoss verringern. Pilotprojekte sind für das Jahr 2023 geplant.
«Die grösste Herausforderung bei der Blockchain-Technologie besteht darin, ihren Nutzwert aufzuzeigen, damit in der Branche Akzeptanz auf breiterer Basis entsteht», so Cuomo. «Es braucht viel Überzeugungsarbeit.»
Die Mitglieder des Teams sind davon überzeugt, dass sich ihre Bemühungen lohnen und dass sich die Zusammenarbeit in den kommenden Jahren auszahlen wird. Aus diesem Grund haben sie einen gemeinnützigen Verein mit Sitz in der Schweiz gegründet, der das IMI-Projekt auch in Zukunft weiterführen wird. Jetzt arbeiten sie daran, Partner für den Verein zu gewinnen.
«Es gibt viele Bereiche, in denen die Blockchain-Technologie zum entscheidenden Faktor werden könnte», so Fritz. «Sobald elektronische Produktinformationen Realität sind, wird es möglich sein, diese in Echtzeit zu aktualisieren oder den Patienten Rückrufinformationen und andere Auskünfte zur Verfügung zu stellen, etwa darüber, wie das Produkt zu entsorgen ist. Wir arbeiten auch an Lösungen zur Bekämpfung von Fälschungen und vielem anderen mehr.»
Präzisionsmedizin
Zwar gibt es noch keine Heilung für die sogenannte Mukoviszidose (auch zystische Fibrose, CF), doch es sind mehrere Medikamente auf dem Markt, die dazu beitragen, potenziell lebensbedrohliche Erkrankungen im Zusammenhang mit CF zu bekämpfen, so dass die Patienten, die besonders anfällig für bakterielle Lungeninfektionen sind, ein längeres und gesünderes Leben führen können. Mit einer Reihe von in der Entwicklung befindlichen Therapeutika, die auf die molekularen Defekte abzielen, die der Krankheit zugrunde liegen, wird sich die medizinische Versorgung von Mukoviszidose wahrscheinlich weiter verbessern.
Ein grosses Hindernis bei der Behandlung von Mukoviszidose ist die enorme Variabilität der Mutationen, die die genetische Codierung des CFTR-Proteins (Cystic Fibrosis Transmembrane Conductance Regulator) betreffen. Bislang wurden über 2000 CFTR-Mutationen identifiziert, die zu unterschiedlichen klinischen Phänotypen führen. Daher besteht Bedarf an einem präzisen, schnellen Diagnoseinstrument, das Ärzte dabei unterstützt, das für die Patienten am besten geeignete Medikament zu bestimmen.
Um dieses Problem zu lösen und individuell zugeschnittene Therapien anzubieten, arbeitet Nathalie Brandenberg, Wissenschaftlerin an der École polytechnique fédérale de Lausanne (EPFL), die 2017 ein FreeNovation-Stipendium erhalten hat, derzeit an einem biotechnisch hergestellten rektalen Organoid-System, das als Surrogat für die Beurteilung der therapeutischen Wirksamkeit dienen soll.
Rektale Organoide sind primäre In-vitro-Stammzellkulturen. Brandenberg und ihr Team generieren solche Zellkulturen aus Zellproben von Patienten mit Mukoviszidose, um die individuellen Reaktionen auf zugelassene CFTR-modulierende Medikamente zu untersuchen.
«Mit anderen Worten: Je nachdem, wie die Organoide ansprechen, kann dem Patienten eine gezielte Behandlung angeboten werden», so Brandenberg, die das Projekt an der EPFL leitet. Ihr Team hat zunächst erfolgreich Darmepithel-Organoide aus Mäusen gewonnen, bevor man zu Versuchen mit menschlichen Zellen überging.
«Unsere Forschung fällt in den Bereich der translationalen Medizin, da wir bestrebt sind, die Grundlagenforschung mit der medizinischen Praxis zu verbinden», so Brandenberg. Über ihre Arbeit merkt sie aus klinischer Sicht Folgendes an: «Organoide, die als Modelle dienen, ermöglichen es uns, das wirksamste therapeutische Konzept zu ermitteln und massgeschneidert zu gestalten – insbesondere für Patienten mit seltenen CFTR-Mutationen, für die es keine hinreichenden Therapieoptionen gibt.»
Das Ziel von Brandenberg und ihrem Team ist es, nach Abschluss der Versuche ihren In-vitro-Diagnosetest auf den Markt zu bringen, um Mukoviszidose-Patienten einen besseren Zugang zu innovativen Behandlungen zu ermöglichen, und zwar auf minimalinvasive und kostengünstige Weise.